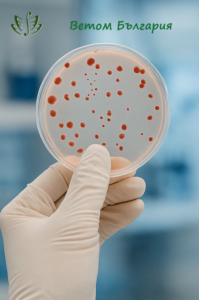

Лятото с Ветом
Лятото с

🔬 Ветом – пробиотикът с доказана ефикасност!!
🌿 Доставен от Новосибирск, с грижа за българското здраве.
📈 Последните изследвания показват:
✔️ Ветом поддържа баланса на чревната микрофлора.
✔️ Подпомага имунната система при стрес, болест и възстановяване.
✔️ Потиска патогенни бактерии без да засяга полезните.
📢 Ново: Резултати от клинични изпитания потвърдиха:
Ветом значително ускорява възстановяването след вирусни инфекции.
🧪 Пациенти приемали Ветом 2 ежедневно показват:
– 42% по-бързо възстановяване.
– 38% по-малко усложнения.

🤔 Какво прави Ветом уникален?
👉 Съдържа живи щамове на бактериите Bacillus, активни в стомашно-чревния тракт.
👉 Натурален, без странични ефекти, съвместим с всяка диета.
👉 Подходящ за ежедневен прием и профилактика.
🇧🇬 В България – само от официалния дистрибутор:
🛒 За поръчки!
![]()

📦 Гарантиран произход, бърза доставка.
🤝 Саномед Интернешънъл – доверие, качество, подкрепа!
🌱 Изберете Ветом – защото здравето започва отвътре!!
💊 Вземете своя курс още днес на www.vetom.bg

Стефан Спасов +359 879 28 95 58 🟢 📲 WhatsApp / Viber




























